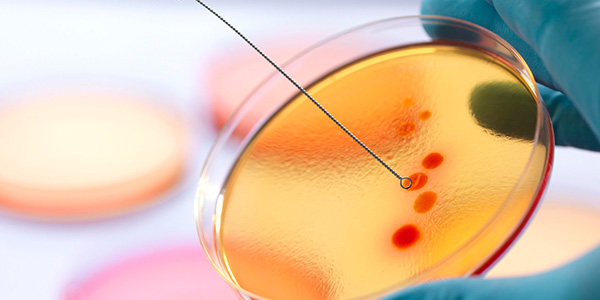

L'analisi del Dna libero circolante può però essere utile anche molto prima, in assenza di tumori

La conferma arriva dallo studio “Prevenzione e Salute", presentato stamattina a Roma
PALERMO (ITALPRESS) – Aumenta in Italia la percentuale di sopravvivenza a tumori che fino a qualche anno fa non davano scampo. Questo grazie alla ricerca e alle nuove terapie immunoterapiche che per certe neoplasie si sono rivelate decisive. A parlare di “dati confortanti” è Livio Blasi, da poco più di un mese nuovo presidente del […]

Insieme a lui è stato nominato il nuovo collegio direttivo

Una dieta a basso contenuto glicemico, associata ai farmaci, può favorire un meccanismo biomolecolare che può "far morire di fame" le cellule tumorali

Con circa 12.000 decessi l'anno, i tumori rappresentano la seconda causa di morte nell'isola, dopo le patologie cardio-vascolari

Un meccanismo molecolare sarebbe la causa del diffondersi di metastasi al cervello

Alla base di questi importanti risultato c'è un miglior avvicinamento ai programmi di screening, una efficacia delle campagne di prevenzione e i passi in avanti registrati dall'oncologia di precisione

L'insorgere del cancro è il risultato di mutazioni del Dna. I ricercatori olandesi hanno studiato le mutazioni del Dna nelle cellule staminali adulte di fegato, intestino e colon di una serie di volontari tra i 3 e gli 87 anni

Lo studio è stato condotto nella Columbia University di New York da un gruppo di scienziati, guidati dall'italiano Antonio Lavarone
"La ricerca è spostata sui farmaci innovativi mentre sulla resistenza agli antibiotici, che sono la prima causa di morte al mondo, non sono stati fatti grandi passi avanti", ha spiegato la Lorenzin

Lo studio è stato descritto a Washington da tre ricercatori nel corso dell'incontro annuale dell'American Association for the Advancement of Science (AAAS)

"Si potrà continuare a filtrare via le cellule pericolose dall’organismo, prolungando così la vita del paziente. Il biochip porterà una rivoluzione nel trattamento del cancro", spiega un ricercatore

Peccato però che questi risultati non siano noti agli italiani, rileva il presidente Aiom Carmine Pinto

Sarà sviluppata anche una app con giochi e quiz per illustrare ai ragazzi la pericolosità di questo vizio e i benefici che derivano da stili di vita sani

Presentata a Milano 'Sam - Salute al Maschile", una campagna di prevenzione dei tumori (ma non solo) dedicata agli uomini e voluta dalla Fondazione Veronesi, insieme agli urologi delle società scientifiche Auro e Siuro

Il modello si basa sulle replicazioni del Dna delle staminali di vari tessuti, che possono dar vita a mutazioni casuali che portano al cancro

Gli esperti hanno dimostrato l'esistenza di una molecola in grado di intossicare le cellule che causano il tumore della tiroide, costringendole a "bere" liquidi, in modo così massiccio da portarle alla loro "esplosione". Le cellule, troppo piene, letteralmente "scoppiano

La denuncia viene dal sesto rapporto annuale sulla condizione dei malati presentato dalla federazione delle associazioni di volontariato (Favo) oggi a Roma in occasione della Giornata nazionale del malato oncologico

La prevenzione oncologica 'va allo stadio', nel tentativo di far capire ai tifosi l'importanza dell'attività fisica praticata, oltre a quella vista dalle gradinate. L'iniziativa, che partirà il prossimo sabato dall'Olimpico di Roma
